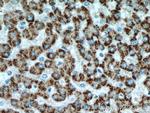
ACOX1 Antibody in Immunohistochemistry (Paraffin) (IHC (P))

Search
Proteintech
ACOX1 Polyclonal Antibody
{{$productOrderCtrl.translations['antibody.pdp.commerceCard.promotion.promotions']}}
{{$productOrderCtrl.translations['antibody.pdp.commerceCard.promotion.viewpromo']}}
{{$productOrderCtrl.translations['antibody.pdp.commerceCard.promotion.promocode']}}: {{promo.promoCode}} {{promo.promoTitle}} {{promo.promoDescription}}. {{$productOrderCtrl.translations['antibody.pdp.commerceCard.promotion.learnmore']}}

Please note: We are reviewing Western blot images included in the antibody testing data in our catalog, including those provided by third parties. Unless expressly labeled or annotated as “raw-unedited”, Western blot images included in the antibody testing data in our catalog may have been edited, optimized or otherwise adjusted for presentation.
产品信息
10957-1-AP
种属反应
已发表种属
宿主/亚型
分类
类型
抗原
偶联物
形式
浓度
规格
纯化类型
保存液
内含物
保存条件
运输条件
产品详细信息
Immunogen sequence: YGTMVFVRS FLVGEAARAL SKACTIAIRY SAVRHQSEMK PGEPEPQILD FQTQQYKLFP LLATAYAFQF VGAYMKETYH RINEGIGQGD LSELPELHAL TAGLKAFTSW TANTGIEACR MACGGHGYSH CSGLPNIYVN FTPSCTFEGE NTVMMLQTAR FLMKSYDQVH SGKLVCGMVS YLNDLPSQRI QPQQVAVWPT MVDINSPESL TEAYKLRAAR LVEIAAKNLQ KEVIHRKSKE VAWNLTSVDL VRASEAHCHY VVVKLFSEKL LKIQDKAIQA VLRSLCLLYS LYGISQNAGD FLQGSIMTEP QITQVNQRVK ELLTLIRSDA VALVDAFDFQ DVTLGSVLGR YDGNVYENLF EWAKNSPLNK AEVHESYKHL KSLQSKL (275-660 aa encoded by BC010425 )
靶标信息
The protein encoded by this gene is the first enzyme of the fatty acid beta-oxidation pathway, which catalyzes the desaturation of acyl-CoAs to 2-trans-enoyl-CoAs. It donates electrons directly to molecular oxygen, thereby producing hydrogen peroxide. Defects in this gene result in pseudoneonatal adrenoleukodystrophy, a disease that is characterized by accumulation of very long chain fatty acids. Alternatively spliced transcript variants encoding different isoforms have been identified.
仅用于科研。不用于诊断过程。未经明确授权不得转售。
生物信息学
蛋白别名: ACO; acyl-Coenzyme A oxidase 1, palmitoyl; AOX; Palmitoyl-CoA oxidase; Peroxisomal acyl-coenzyme A oxidase 1; Peroxisomal fatty acyl-CoA oxidase; peroxisomal fatty acyl-coenzyme A oxidase; peroxisomal straight-chain Acyl-CoA oxidase; SCOX; Straight-chain acyl-CoA oxidase
基因别名: ACOX; ACOX1; AOX; D130055E20Rik; Paox; RATACOA1
UniProt ID: (Rat) P07872, (Mouse) Q9R0H0
Entrez Gene ID: (Rat) 50681, (Mouse) 11430




